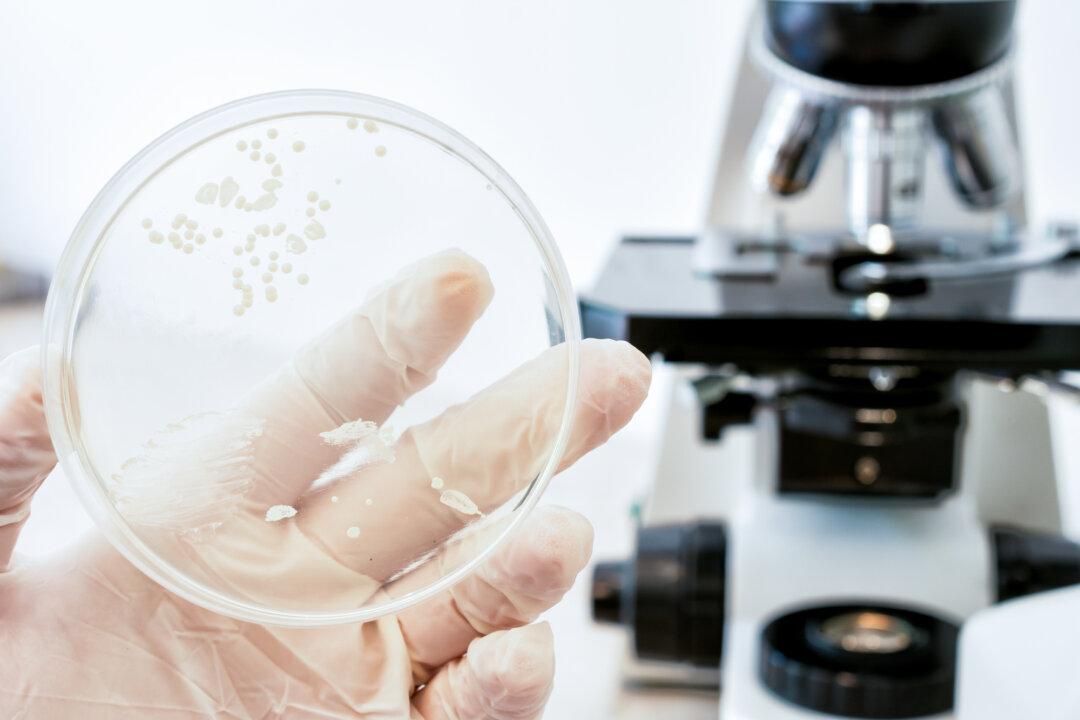
Candida: A Fungus We All Carry That Can Lead to Most Common Fungal Infections, Tips to Fight It

Candida albicans is a type of fungus that causes some of the most common fungal diseases. The drug-resistant strain has received a lot of attention, but the majority of cases are caused by the yeast’s more easily treated forms. Let’s look at what’s known about this disease, what it can do to us, and what can be done about it.
We All Carry It
Everyone carries a small amount of Candida. Normal strains of Candida are usually present in small amounts in our mouths, digestive tract, and skin.Problems start when the balance of microorganisms in our bodies is disrupted; then Candida can overgrow, which causes infection.